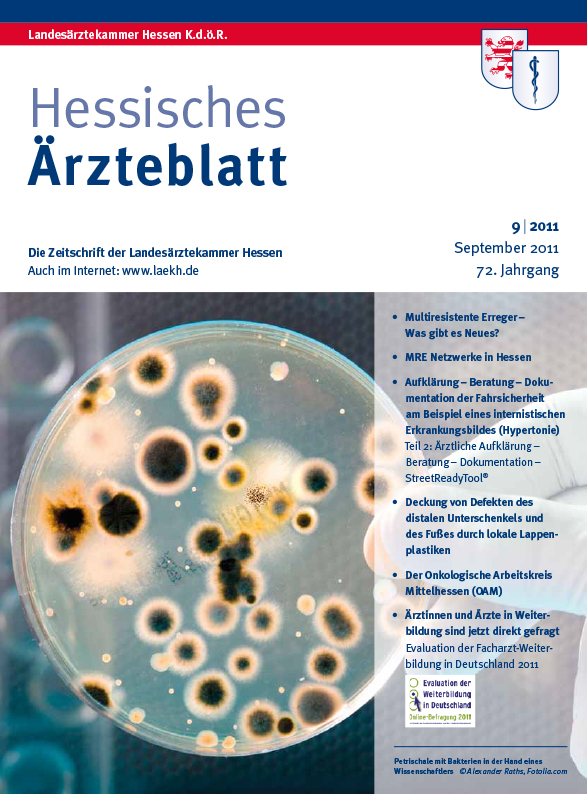

Ab dem 01.09.2023 erhalten Sie das Hessische Ärzteblatt in der digitalen Form. Sie möchten weiterhin die gedruckte Version erhalten? Weitere Infos finden Sie hier!
Issuearchive
Heftarchiv
Über das Auswahlfeld "Jahrgang" gelangen Sie auf die einzelnen Jahrgangsübersichten. Mit Klick auf die Titelbilder öffnen Sie die jeweilige Ausgabe.
Auf der Seite Autoren können Sie nach Artikeln von bestimmten Autoren ab der Ausgabe Januar 2020 suchen.
Service
-
Redaktion
Infos zur Redaktion finden Sie hier.
-
Autorenhinweise
Autorinnen und Autoren, die Beiträge für das Hessische Ärzteblatt (HÄBL) einreichen, bitten wir, die Hinweise zu beachten, die wir auf dieser Seite zusammengestellt haben.
Stellenangebote und -gesuche, die im Hessischen Ärzteblatt geschaltet wurden, finden Sie auf der Seite Ärztestellen.
-
Anzeigenservice
Informationen zum Schalten von Anzeigen, zur Reichweite und zu den Anzeigenpreisen finden Sie auf der Seite Anzeigenservice.
Stellenangebote und -gesuche, die im Hessischen Ärzteblatt geschaltet wurden, finden Sie auf der Seite Ärztestellen.
-
Adressänderung
Ihre Adresse hat sich geändert? Die Änderung Ihrer Anschrift müssen Sie der zuständigen Bezirksärztekammer melden. Weitere Infos dazu gibt es auf der Seite Änderungsmeldung.